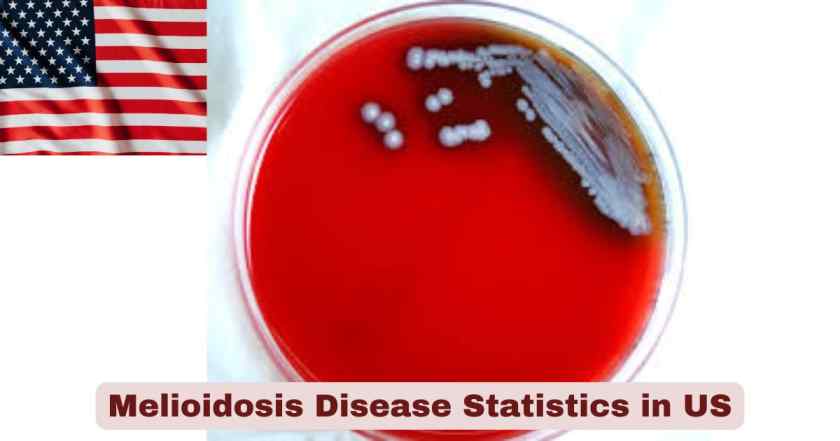
Melioidosis Disease Statistics in US 2025 | Key Facts

Melioidosis Disease in US 2025
Melioidosis disease represents an emerging public health concern within the United States that demands heightened awareness from medical professionals, public health officials, and at-risk populations. This bacterial infection, caused by Burkholderia pseudomallei, has traditionally been associated with tropical regions of Southeast Asia and northern Australia. However, recent discoveries have fundamentally altered our understanding of this pathogen’s geographic distribution within American territories. The bacteria now has confirmed environmental presence in the Gulf Coast region of Mississippi, Puerto Rico, and the U.S. Virgin Islands, marking the first time these organisms have been identified in the continental United States outside of travel-associated cases.
The significance of melioidosis in the US extends beyond mere case counts. This disease poses unique diagnostic challenges because it masterfully mimics other common infections, earning its reputation as “the great mimicker” among infectious disease specialists. The clinical presentations range from localized skin infections to severe pneumonia and life-threatening sepsis, making early recognition critical for patient survival. With mortality rates ranging from less than 10% with prompt treatment and intensive care to over 40% without appropriate antibiotics, the stakes for accurate diagnosis remain extraordinarily high. Understanding the current epidemiology, transmission patterns, risk factors, and clinical outcomes of melioidosis has become essential for healthcare providers throughout the southern United States and U.S. territories where environmental exposure risks now exist.
Interesting Facts and Latest Melioidosis Disease Statistics in US 2025
| Fact Category | Statistic/Information | Year/Period |
|---|---|---|
| Annual Cases | Approximately 12 cases identified annually | 2025 |
| Endemic Locations in US | Mississippi Gulf Coast, Puerto Rico, U.S. Virgin Islands | 2025 |
| First Environmental Detection | Gulf Coast region of Mississippi | 2022 |
| Travel-Associated Cases | 64% of cases linked to travel to endemic areas | 2008-2013 |
| Mortality Rate with Treatment | Less than 10% with early recognition and intensive care | 2025 |
| Mortality Rate without Treatment | Greater than 40% without appropriate antibiotics | 2025 |
| Incubation Period Range | 1 to 21 days (median 4 days) | 2025 |
| Symptom Development Timeframe | Typically 1 to 3 weeks after infection | 2025 |
| Georgia Cluster Cases | 4 cases identified from 1983 through 2024 | 1983-2024 |
| Hurricane Helene Impact | 2 cases in Georgia following September 2024 landfall | 2024 |
| Aromatherapy Outbreak Cases | 4 linked cases including 2 deaths | 2021 |
| Nationally Notifiable Condition | Designated by CSTE | 2023 |
| Select Agent Designation | Tier 1 select agent status | Current |
| Primary Risk Age Group | 40 to 60 years of age | Endemic regions |
| Pediatric Cases | Fewer than 5% occur in children under 5 years | Endemic regions |
| Laboratory Exposure Risk (High) | 16% of 261 exposed persons | 2008-2013 |
| Laboratory Exposure Risk (Low) | 50% of 261 exposed persons | 2008-2013 |
| Diabetes as Risk Factor | Most common underlying condition | 2025 |
| Pulmonary Involvement | More than 50% of cases | 2025 |
Data source: Centers for Disease Control and Prevention (CDC), Emerging Infectious Diseases Journal, CDC Health Alert Network, MMWR Surveillance Summaries, 2008-2025
The statistics presented illuminate several critical aspects of melioidosis in the United States in 2025. The relatively small number of approximately 12 annual cases underscores why many American physicians remain unfamiliar with this disease, yet this unfamiliarity poses significant diagnostic challenges. The 64% travel-association rate demonstrates that most infections still result from exposure in traditionally endemic regions, though domestic cases are increasingly recognized. The stark contrast between mortality rates—less than 10% with proper treatment versus over 40% without—emphasizes the life-or-death importance of rapid diagnosis and appropriate antibiotic selection.
Recent events have transformed the landscape of melioidosis risk in the US. The discovery of B. pseudomallei in Mississippi Gulf Coast soil and water in 2022 represented a watershed moment, confirming for the first time that these bacteria exist naturally in continental American environments. The four linked cases in 2021 from an imported aromatherapy spray demonstrated how commercial products can introduce this pathogen to areas where it doesn’t occur naturally. Most alarmingly, the two Georgia cases following Hurricane Helene in September 2024 highlight how severe weather events can activate dormant bacteria or increase exposure through flooding and contaminated soil dispersal. The median incubation period of 4 days means that public health officials must remain vigilant for weeks following major hurricanes or flooding events in at-risk regions.
Annual Melioidosis Case Trends in the US 2008-2025
| Year Range | Confirmed Cases | Travel-Associated | Domestically Acquired | Notable Events |
|---|---|---|---|---|
| 2008-2013 | 37 confirmed cases | 64% | 2 cases reported | Surveillance period with occupational exposures |
| 2019 | 1 case | No recent travel | Domestic | Maryland aquarium-associated case |
| 2020 | 1 case | No recent travel | Domestic | Mississippi Gulf Coast first detection |
| 2021 | 4 cases | No recent travel | Domestic | Aromatherapy spray outbreak, 2 deaths |
| 2022 | 1 case | No recent travel | Domestic | Mississippi second confirmed case |
| 2023 | Designated NNC | Variable | Variable | Melioidosis becomes nationally notifiable |
| 2024 | 2 cases in Georgia | No recent travel | Domestic | Hurricane Helene-associated infections |
| 2025 | ~12 cases (projected) | Majority travel-linked | Ongoing surveillance | Enhanced monitoring in Gulf Coast region |
Data source: CDC MMWR Surveillance Summaries, CDC Emerging Infectious Diseases Journal, CDC Health Alert Network, 2008-2025
The trend data reveals a concerning evolution in melioidosis epidemiology within the United States from 2008 to 2025. During the 2008-2013 surveillance period, public health authorities documented 37 confirmed cases, with the majority linked to international travel. Only two persons reported no travel outside the United States during this timeframe, suggesting that domestic acquisition was exceedingly rare. This pattern aligned with the longstanding understanding that melioidosis represented an imported disease rather than a domestic threat.
However, the period from 2019 through 2025 tells a dramatically different story. Beginning with the Maryland aquarium case in 2019, followed by the Mississippi environmental detection in 2020, the aromatherapy outbreak affecting four states in 2021, and culminating with Hurricane Helene-associated cases in 2024, domestically acquired infections have become increasingly prominent. The designation of melioidosis as a nationally notifiable condition in 2023 reflects growing recognition of this shifting epidemiology. Current projections estimate approximately 12 cases annually for 2025, though enhanced surveillance may reveal previously unrecognized infections. The geographic expansion from essentially zero endemic areas in the continental US before 2022 to confirmed environmental presence in Mississippi represents one of the most significant developments in American infectious disease epidemiology in recent years.
Geographic Distribution of Melioidosis in the US 2025
| Location | Status | Environmental Detection | Human Cases | Risk Level |
|---|---|---|---|---|
| Mississippi Gulf Coast | Endemic | Confirmed in soil and water (2022) | 3 cases (2020, 2022, linked) | Moderate risk |
| Puerto Rico | Endemic | Bacteria present | Historical cases documented | Moderate to high risk |
| U.S. Virgin Islands | Endemic | Bacteria present | Historical cases documented | Moderate to high risk |
| Georgia | Emerging concern | Under investigation | 4 cases (1983-2024) | Low to moderate risk |
| Kansas | Import-associated | No environmental detection | 1 case (2021 outbreak) | Low risk |
| Minnesota | Import-associated | No environmental detection | 1 case (2021 outbreak) | Low risk |
| Texas | Import-associated | No environmental detection | 1 case (2021 outbreak) | Low risk |
| Maryland | Import-associated | No environmental detection | 1 case (2019 aquarium) | Low risk |
| California | Surveillance area | No environmental detection | 0-4 cases annually (2012-2023) | Low risk |
| Southeastern US | Potential expansion | Modeling suggests suitability | Unknown | Unknown |
Data source: CDC Melioidosis Surveillance, CDC Emerging Infectious Diseases, State Health Departments, 2019-2025
The geographic distribution data paints a complex picture of melioidosis risk across the United States in 2025. The Mississippi Gulf Coast stands as the only location in the continental United States where B. pseudomallei has been definitively detected in environmental samples. The 2022 discovery of these bacteria in soil and water represented a turning point, confirming that conditions in this region support bacterial survival and potentially reproduction. The three genetically linked cases from this area between 2020 and 2022 provide epidemiologic confirmation that environmental exposure, not travel, caused these infections.
Puerto Rico and the U.S. Virgin Islands have long harbored B. pseudomallei in their environments, making them the only U.S. territories where melioidosis has been endemic for decades. Residents and visitors to these islands face ongoing exposure risks, particularly during rainy seasons or following severe weather events. The Georgia cluster of four cases spanning from 1983 through 2024 raises intriguing questions about whether B. pseudomallei may have existed undetected in this county for over four decades. Two of these patients—retired military veterans—died from the disease in 1983 and 1989, while two additional patients developed infections following Hurricane Helene in September 2024. Whole genome sequencing revealed that all four infections stemmed from highly related bacterial strains, strongly suggesting a common environmental source in Georgia that has persisted for at least 41 years. This finding has profound implications, as predictive modeling studies indicate that environmental conditions throughout much of the southeastern United States could support B. pseudomallei survival, potentially indicating a far broader geographic distribution than currently recognized.
Risk Factors for Melioidosis in the US 2025
| Risk Factor Category | Specific Condition/Exposure | Relative Risk | Prevalence in Cases |
|---|---|---|---|
| Diabetes Mellitus | Type 1 or Type 2 diabetes | Highest medical risk factor | Most common comorbidity |
| Heavy Alcohol Use | Excessive alcohol consumption | Significantly elevated | Second most common |
| Chronic Kidney Disease | Renal disease or dysfunction | Significantly elevated | Common comorbidity |
| Chronic Liver Disease | Cirrhosis or hepatic dysfunction | Elevated | Documented risk factor |
| Chronic Lung Disease | COPD, cystic fibrosis, bronchiectasis | Elevated | Associated with poor outcomes |
| Thalassemia | Blood disorder | Elevated risk | Rare in US |
| Cancer/Immunosuppression | Active malignancy or immunodeficiency | Elevated | Associated with severe disease |
| Travel to Endemic Areas | Southeast Asia, Northern Australia | 64% of historical cases | Primary exposure route |
| Hurricane/Severe Weather | Exposure to floodwater or contaminated soil | Elevated during/after events | 3 of 4 Georgia cases |
| Occupational Exposure | Agriculture, construction, military | Variable | Common in endemic regions |
| Age 40-60 Years | Middle-aged adults | Higher incidence | Peak age range |
| Open Wounds | Cuts, scrapes, skin breaks | Direct inoculation route | Contact with soil/water |
Data source: CDC Clinical Overview, CDPH Melioidosis Guidance, CDC Emerging Infectious Diseases, 2023-2025
Risk factors for melioidosis in the United States encompass both host susceptibility factors and environmental exposure circumstances. Diabetes mellitus emerges as the single most important predisposing medical condition, appearing in a substantial proportion of confirmed cases. The mechanism involves impaired immune function and potentially increased bacterial adherence to tissues in hyperglycemic states. Heavy alcohol use ranks as the second most significant comorbidity, with research demonstrating that even single binge-drinking episodes can impair lung immune defenses against B. pseudomallei. Chronic kidney disease substantially increases both infection risk and mortality, likely through combined effects of uremia-related immune dysfunction and frequent healthcare encounters.
Environmental and exposure-related risks have evolved significantly in 2025. While travel to Southeast Asia or Northern Australia historically accounted for 64% of U.S. cases during the 2008-2013 surveillance period, domestic environmental exposures now constitute an increasing proportion. Severe weather events, particularly hurricanes, represent a critical and underappreciated risk factor. In the Georgia cluster, three of the four patients developed illness following or in association with hurricane events—Hurricane Hugo in 1989 and Hurricane Helene in 2024. These powerful storms generate conditions that bring soil bacteria to the surface, create aerosolized contaminated water droplets, and produce flooding that facilitates widespread exposure. The 40 to 60 years age range demonstrates highest incidence, possibly reflecting cumulative exposure over decades combined with age-related immune changes and accumulation of comorbidities.
Clinical Manifestations and Mortality Outcomes in US 2025
| Clinical Presentation | Frequency | Mortality Rate | Treatment Duration | Key Features |
|---|---|---|---|---|
| Pulmonary Melioidosis | >50% of cases | <10% with ICU care | 2-8 weeks IV + 3-6 months oral | Most common presentation |
| Localized Skin Infection | Variable | Lower with treatment | 2-8 weeks IV + 3-6 months oral | Ulcers, abscesses, swelling |
| Disseminated Disease | Severe cases | 4.93x increased odds of death | Extended therapy required | Multiple organ involvement |
| Septicemia | Severe cases | >40% without treatment | Critical care required | Life-threatening complication |
| Neurological Melioidosis | Rare, severe | Very high without treatment | Prolonged therapy | Brain abscesses, encephalitis |
| Musculoskeletal | Variable | Lower with treatment | Extended therapy | Septic arthritis, osteomyelitis |
| Acute ARDS | Complication | Poor prognosis indicator | Intensive care required | Respiratory failure |
| Latent/Reactivation | Long-term | Variable | Standard therapy | Can occur years after exposure |
| Chronic Melioidosis | 9% of cases | Variable | >2 months symptoms | Prolonged, indolent course |
Data source: CDC Clinical Overview, Emerging Infectious Diseases Journal, PLOS Neglected Tropical Diseases, 2024-2025
Clinical manifestations of melioidosis present enormous diagnostic challenges because no single pattern predominates. Pulmonary melioidosis represents the most frequent presentation, accounting for more than 50% of all cases. Patients typically develop acute pneumonia with fever, cough, chest pain, and dyspnea that can rapidly progress to respiratory failure. Chest radiographs may show consolidation, cavitation, or abscess formation that mimics tuberculosis or other bacterial pneumonias. The mortality rate for pulmonary disease remains under 10% when patients receive appropriate intensive care and antibiotics, but delays in diagnosis can prove catastrophic.
Disseminated disease dramatically worsens prognosis, with studies documenting 4.93 times higher odds of death compared to localized infections. This form involves multiple organ systems simultaneously, potentially affecting the liver, spleen, prostate, kidneys, bones, joints, lymph nodes, and brain. Septicemia, the presence of bacteria in the bloodstream causing systemic infection, represents the most immediately life-threatening complication. Without prompt recognition and treatment with appropriate antibiotics, mortality exceeds 40%. Treatment requires an intensive phase of 2 to 8 weeks of intravenous antibiotics (typically ceftazidime or meropenem), followed by an eradication phase of 3 to 6 months of oral antibiotics (usually trimethoprim-sulfamethoxazole). The prolonged treatment duration reflects the bacteria’s ability to survive intracellularly and form abscesses that antibiotics penetrate poorly. Chronic melioidosis, defined as symptoms persisting more than 2 months, occurs in approximately 9% of cases and may represent smoldering infection or treatment failure. Some patients develop reactivation of latent infection months or even years after initial exposure, particularly when immune function declines due to illness, medications, or aging.
Treatment Protocols and Antibiotic Regimens in US 2025
| Treatment Phase | Primary Regimen | Duration | Alternative Options | Monitoring Requirements |
|---|---|---|---|---|
| Intensive Phase IV | Ceftazidime 40 mg/kg every 8 hours | 2-8 weeks | Meropenem for severe cases | Blood cultures, clinical response |
| Intensive Phase IV | Meropenem 25 mg/kg every 8 hours | 2-8 weeks | Reserved for ICU/severe sepsis | Organ function monitoring |
| Eradication Phase Oral | TMP-SMX 320/1600 mg twice daily | 3-6 months | Ensure complete treatment | Regular follow-up required |
| Eradication Phase Oral | Amoxicillin-clavulanate 20 mg/kg | 3-6 months | If TMP-SMX allergy/resistance | Monitor for recurrence |
| CNS Infection | Ceftazidime 50 mg/kg every 6 hours | >12 weeks IV | Add TMP-SMX 320/1600 mg | Extended therapy required |
| Post-Exposure Prophylaxis | TMP-SMX for 21 days | 21 days | Doxycycline or amoxicillin-clavulanate if contraindicated | For high-risk lab exposures |
| Supportive Care | ICU admission for severe cases | As needed | Abscess drainage, ventilatory support | Multidisciplinary approach |
| Adjunctive Therapy | Glycemic control, organ support | Entire treatment | Blood pressure maintenance, dialysis | Especially for diabetic patients |
Data source: CDC Treatment Guidelines, CDC Clinical Overview, CDPH Melioidosis Guidance, 2024-2025
Treatment of melioidosis requires prolonged antibiotic courses administered in two distinct phases. The intensive phase utilizes intravenous antibiotics for 2 to 8 weeks, with ceftazidime serving as the first-line agent at doses of 40 mg/kg every 8 hours (maximum 2 grams per dose). For patients with severe sepsis requiring intensive care unit admission, or for central nervous system infections, meropenem at 25 mg/kg every 8 hours (maximum 1 gram per dose) represents the preferred alternative due to superior tissue penetration and bactericidal activity. The duration of the intensive phase depends on disease severity and clinical response, with blood cultures repeated to document bacterial clearance.
The eradication phase follows the intensive phase and continues for 3 to 6 months using oral antibiotics. Trimethoprim-sulfamethoxazole (TMP-SMX) at 320/1600 mg twice daily serves as the standard regimen, with folic acid supplementation to prevent antifolate toxicity. For patients unable to tolerate TMP-SMX due to allergy or in cases where the isolate demonstrates resistance, amoxicillin-clavulanate at approximately 20 mg/kg of the amoxicillin component every 8 hours provides an effective alternative. Treatment adherence during the eradication phase proves critical, as premature discontinuation substantially increases relapse risk. Central nervous system infections require particularly aggressive and prolonged therapy, typically extending beyond 12 weeks of intravenous ceftazidime at higher doses of 50 mg/kg every 6 hours, often with concurrent oral TMP-SMX to enhance CNS penetration.
Post-exposure prophylaxis becomes necessary for laboratory workers or healthcare personnel with high-risk exposures to B. pseudomallei. The standard regimen involves TMP-SMX for 21 days, with doxycycline or amoxicillin-clavulanate serving as alternatives for individuals with contraindications. Supportive care remains equally important, particularly for patients with severe sepsis or disseminated disease. This includes intensive care unit monitoring, mechanical ventilation for respiratory failure, vasopressor support for septic shock, renal replacement therapy for acute kidney injury, and surgical drainage of accessible abscesses. For diabetic patients, meticulous glycemic control may improve outcomes, though definitive evidence remains limited.
Laboratory Diagnosis and Surveillance in US 2025
| Diagnostic Method | Specimen Types | Turnaround Time | Sensitivity | Specificity |
|---|---|---|---|---|
| Bacterial Culture | Blood, sputum, urine, wound swabs, abscess fluid | 2-5 days | Gold standard | Highly specific |
| LRN Algorithm | Positive isolates | 1-2 days | Confirmatory | 100% specific |
| Real-Time PCR | Clinical specimens | 4-6 hours | High sensitivity | High specificity |
| Indirect Hemagglutination | Serum | 1-2 days | Moderate sensitivity | Variable specificity |
| Antibody Titer IHA | Serum (titer >1:40) | 1-2 days | Supportive evidence | Not diagnostic alone |
| Whole Genome Sequencing | Bacterial isolates | 1-2 weeks | Epidemiologic tool | Strain identification |
| MALDI-TOF Mass Spectrometry | Bacterial isolates | Minutes to hours | Rapid identification | Can misidentify |
| 16S rRNA Sequencing | Bacterial isolates | 1-2 days | Genus identification | May not specify species |
Data source: CDC Laboratory Information, CDC Surveillance Guidelines, Laboratory Response Network, 2024-2025
Laboratory diagnosis of melioidosis relies primarily on culture-based methods, with bacterial culture remaining the gold standard. Healthcare providers suspecting melioidosis must collect appropriate specimens including blood, sputum or bronchoscopy specimens, urine, and samples from any potential infection sites such as skin lesions, abscesses, or wounds. The bacteria typically grow on standard laboratory media within 2 to 5 days, though automated identification systems may misidentify B. pseudomallei as other bacteria including Burkholderia cepacia, Burkholderia thailandensis, Chromobacterium violaceum, Ochrobactrum anthropi, or various Aeromonas, Acinetobacter, and Pseudomonas species. This misidentification problem represents a significant diagnostic challenge that can delay appropriate treatment.
The Laboratory Response Network (LRN) algorithm provides confirmatory identification, and because B. pseudomallei holds Tier 1 select agent status, any suspected or confirmed isolate must be immediately reported to state or local public health departments. The LRN algorithm typically requires 1 to 2 days and offers 100% specificity for species confirmation. Real-time PCR assays can detect B. pseudomallei DNA directly from clinical specimens in 4 to 6 hours, providing rapid results that can guide early treatment decisions. However, PCR availability remains limited outside of reference laboratories.
Serologic tests including the Indirect Hemagglutination Assay (IHA) detect antibodies against B. pseudomallei, with titers greater than 1:40 considered positive or a fourfold rise in titer between acute and convalescent specimens indicating recent infection. However, serology alone cannot definitively diagnose acute melioidosis because antibodies may persist from previous exposure or vaccination efforts, and cross-reactivity with other bacteria can produce false-positive results. Whole genome sequencing has emerged as a critical epidemiologic tool, enabling public health investigators to determine whether cases share a common source. This technology proved essential in linking the four aromatherapy-associated cases in 2021, the Mississippi environmental isolates with human cases in 2022, and the four Georgia cases spanning 1983 to 2024. Sequencing typically requires 1 to 2 weeks but provides unparalleled genetic resolution for outbreak investigations and source tracking.
Surveillance systems for melioidosis have strengthened substantially since the designation as a nationally notifiable condition in 2023. The Council of State and Territorial Epidemiologists (CSTE) established standardized case definitions, with probable cases meeting clinical criteria plus supportive laboratory evidence, and confirmed cases requiring isolation of B. pseudomallei from any clinical specimen. Healthcare facilities in jurisdictions where melioidosis is reportable must report cases to local health departments, which then share de-identified information with CDC. Weekly and annual surveillance data appear in the National Notifiable Diseases Surveillance System (NNDSS) data tables, enabling public health officials to monitor trends, identify clusters, and guide prevention efforts.
Hurricane and Severe Weather Impact on Melioidosis Risk in US 2025
| Weather Event Type | Mechanism of Exposure | Risk Period | Documented US Cases | Prevention Measures |
|---|---|---|---|---|
| Category 4-5 Hurricanes | Flooding, wind-driven soil, contaminated water | During and 2-4 weeks post-event | 3 cases documented (Hugo 1989, Helene 2024) | Avoid floodwater and soil contact |
| Heavy Rainfall | Bacteria rise to soil surface | During and 1-3 weeks after | Unknown, likely underrecognized | Wear waterproof boots and clothing |
| Tropical Storms | Flooding and soil disruption | During storm and aftermath | Likely occurs but unquantified | Cover open wounds |
| Severe Flooding | Direct water contact, aerosolization | Duration of flooding + 2-3 weeks | Part of hurricane-associated | Avoid standing water |
| Hurricane Season | June 1 – November 30 annually | Peak risk period | Seasonal pattern observed | Heightened surveillance |
Data source: CDC Emerging Infectious Diseases, CDC About Melioidosis, Georgia Department of Public Health, 2024-2025
Severe weather events, particularly hurricanes, represent a critical and underappreciated trigger for melioidosis infections in areas where B. pseudomallei exists in the environment. The mechanism involves multiple pathways of increased exposure: heavy rainfall brings bacteria from deeper soil layers to the surface, flooding creates extensive standing water contaminated with the organism, high winds aerosolize bacteria-laden soil and water creating infectious droplets, and the physical damage from storms creates numerous opportunities for percutaneous inoculation through cuts, scrapes, and other skin breaks. In endemic regions of Thailand and Australia, researchers have documented clear seasonal patterns with case numbers spiking during and immediately following the rainy season and hurricane events.
The United States data now confirms similar patterns domestically. Of the four Georgia melioidosis cases spanning 1983 to 2024, three occurred in association with hurricanes. One patient developed illness following Hurricane Hugo in September 1989, which made landfall as a Category 4 storm and brought 3 to 5 inches of rain to the affected Georgia county. The two 2024 patients both developed melioidosis after Hurricane Helene struck Georgia in September 2024 as a Category 4 hurricane, producing heavy rainfall, extensive flooding, and wind speeds reaching 100 mph. Both patients worked at the same facility and performed duties involving contact with vehicles, mud, and outdoor areas exposed to the storm’s impact. The timing of their illness onset, occurring within the typical 1 to 21 day incubation period following the hurricane, strongly implicates the severe weather event as the exposure source.
These documented cases likely represent only a fraction of hurricane-associated melioidosis infections. Many cases may go unrecognized due to physician unfamiliarity with the disease, particularly in areas like Georgia where melioidosis was not previously known to occur. The Atlantic hurricane season extends from June 1 through November 30 annually, creating a defined period of elevated risk for residents of the Gulf Coast and southeastern United States. Climate change may be expanding the geographic range of conditions suitable for B. pseudomallei survival while simultaneously increasing the frequency and intensity of hurricanes, potentially compounding melioidosis risk in previously unaffected regions. Public health authorities now recommend that clinicians maintain heightened suspicion for melioidosis in patients presenting with compatible illnesses who have had contact with floodwater, mud, or debris in the 2 to 4 weeks following severe weather events in at-risk areas.
Occupational and Laboratory Exposure Risks in US 2025
| Occupation/Setting | Exposure Type | Number of Exposures (2008-2013) | Risk Level Distribution | Post-Exposure Prophylaxis Need |
|---|---|---|---|---|
| Clinical Laboratory Workers | Specimen handling | 261 persons at risk | High: 16%, Low: 50%, Unknown: 34% | 21 days TMP-SMX for high-risk |
| Agricultural Workers | Soil and water contact | Not quantified | Variable, dependent on location | Avoid contact if endemic area |
| Construction Workers | Soil disruption | Not quantified | Variable, dependent on location | Protective equipment in endemic areas |
| Military Personnel | Field operations, deployment | Historical cases documented | Variable based on deployment | Travel-related primarily |
| Gardeners/Landscapers | Regular soil contact | Not quantified | Moderate in endemic areas | Wear protective boots and gloves |
| Research Laboratory Workers | Deliberate organism handling | 6 incidents (2008-2013) | 2 incidents had occupational exposure | Strict BSL-3 protocols required |
| Healthcare Workers | Patient care exposure | Rare, requires body fluid contact | Very low with standard precautions | Only with breaches in protection |
| Hurricane Response Workers | Floodwater and debris | Elevated post-hurricane | Elevated during response activities | Protective equipment critical |
Data source: CDC MMWR Surveillance Summaries 2008-2013, CDC Laboratory Information, Occupational Safety Guidelines, 2024-2025
Occupational exposures to B. pseudomallei encompass both clinical laboratory incidents and field-based environmental contact. Between 2008 and 2013, CDC documented 261 persons at risk for occupational exposure during laboratory diagnostic procedures for melioidosis cases. Of these individuals, 16% experienced high-risk exposures that warranted immediate post-exposure prophylaxis, 50% had low-risk exposures requiring evaluation and potential prophylaxis based on host risk factors, and 34% fell into undetermined or unknown risk categories. High-risk exposures include needlestick injuries, mucous membrane splashes, procedures generating aerosols without appropriate respiratory protection, or work conducted outside of biological safety cabinets. The relatively high proportion of laboratory exposures reflects the reality that melioidosis often escapes initial diagnostic consideration, leading laboratory personnel to handle specimens without appropriate select agent precautions.
Research laboratory settings reported six incidents of possible occupational exposure during the surveillance period, with two incidents involving confirmed occupational exposures, though notably no human infections resulted. The absence of infections likely reflects rapid implementation of post-exposure prophylaxis protocols and the low overall transmission rate even with exposure. Research facilities working with B. pseudomallei must follow Biosafety Level 3 (BSL-3) containment practices and register with the Federal Select Agent Program, which regulates possession, use, and transfer of dangerous pathogens. Laboratories that identify or suspect B. pseudomallei must immediately contact their state or local public health department and ensure specimens are appropriately labeled to protect downstream personnel.
Disclaimer: The data research report we present here is based on information found from various sources. We are not liable for any financial loss, errors, or damages of any kind that may result from the use of the information herein. We acknowledge that though we try to report accurately, we cannot verify the absolute facts of everything that has been represented.